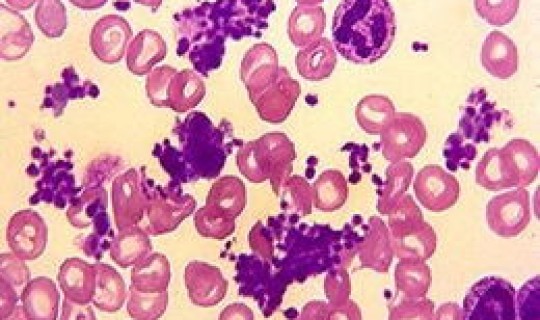
apv病毒 apv是什么意思

当前位置:首页 > 病毒 第155页
-

陕西最新传染病毒,陕西病毒感染最新消息
本文目录陕西新增6例本土确诊病例,其传染源是什么陕西省哪里疫情严重传染病有哪些一、陕西新增6例本土确诊病例,其传染源是什么引言:...
-
apv病毒 apv是什么意思
一、apv是什么 APV病毒被称为鸟类多瘤病毒。资料扩展:鸟类多瘤病毒,别名法兰西斯掉羽症,是一种鸟类疾病。此疾病首先发现在19...
-

新冠病毒德尔塔毒株症状潜伏期多久(现在的新冠病毒潜伏期最长多久)
一、新冠病毒德尔塔变异毒株会消失吗奥秘克戎载具全球疫情的94%,那么德尔塔变异毒株真的消失了吗?大家都知道新冠病毒一直在变异由之...
-

31省区市新增4例本土病例疫情?诺如病毒多少例为疫情
一、31省份新增确诊22例,本土4例在辽宁,零号传染源在哪 31省份新增确诊22例,本土4例在辽宁,零号传染源还在追溯当中,很可...
-

南京疫情病毒为德尔塔毒株症状如何(埃博拉病毒是什么症状)
一、南京此轮疫情传播为德尔塔毒株,这种毒株有什么特点南京此轮疫情是德尔塔毒株。这种毒株的特点是传播速度更强、病毒载量相对比较高、...
-

今年还有病毒吗?最近有没有什么病毒
一、2024年还有新冠病毒吗 1.新冠病毒出现并持续蔓延已超过两年,目前许多国家的疫情仍然严重。2.新冠疫情对我们的生活和工作产...
-

广东最新病毒感染什么症状 新型病毒的症状是怎样的?
一、广东1例英国输入病例中发现突变株,病人有何症状广东发现了一例英国输入病例,这个是具有突变株的,虽然传播力更强,但是这名从英国...
-

上海首个变异病毒死亡 上海有病毒吗
一、英国变异攻入中国,大温居民回上海确诊,变异病毒该如何防范据《中国日报》报道,根据中国疾病预防控制中心2020年12月30日发...
-

2024年8月爆发新的大流行病毒吗叫什么名字?2024年8月爆发新的大流行病毒吗
本文目录2024年8月爆发新的大流行病毒吗请问最近流行的病毒叫什么名字目前广州流行的病毒叫什么名字西瓜银斑驳病毒病病害的传播流行...
-

新冠病毒哪来的源头在哪里(新冠的源头到底在哪儿)
本文目录新冠的源头到底在哪儿新冠病毒到底是从哪里来的新冠病毒是从哪儿来的一、新冠的源头到底在哪儿随着新冠肺炎疫情的全球大流行,有...
















